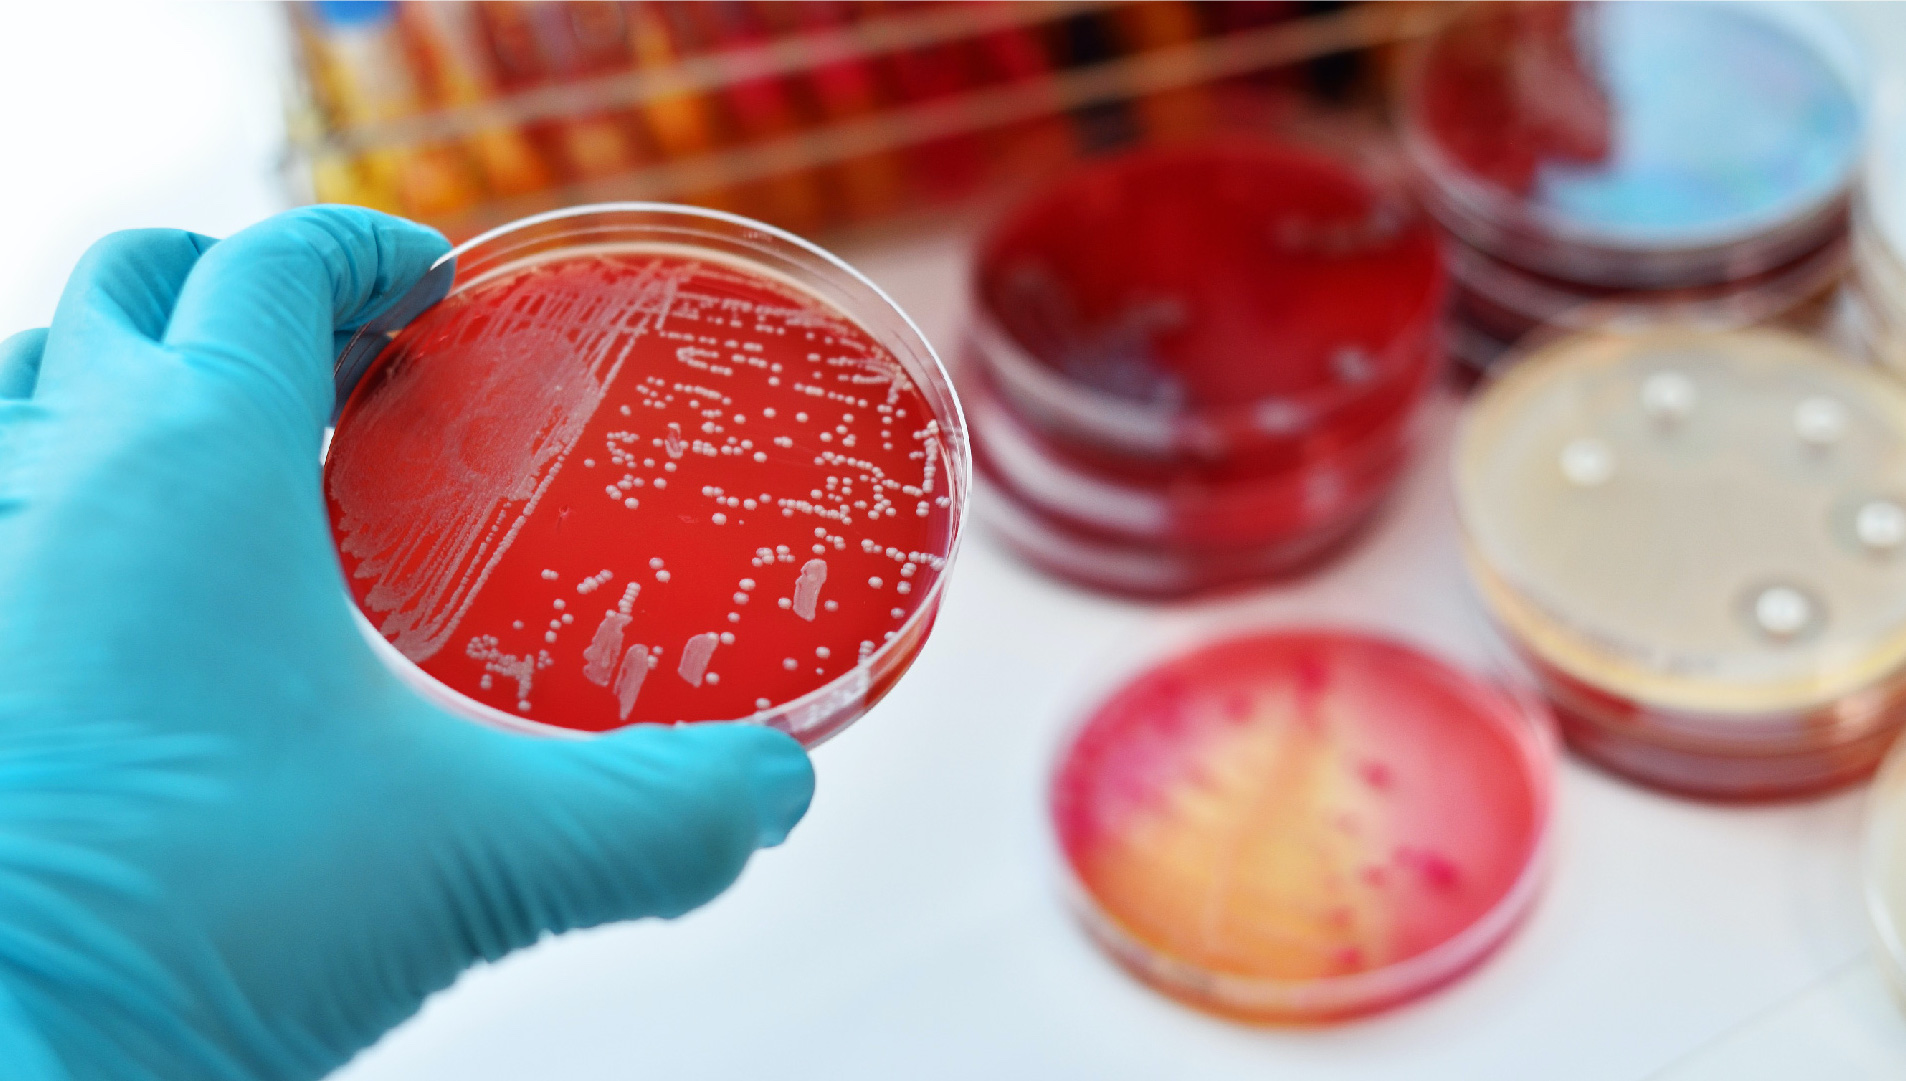
Sintomi infezioni vie urinarie e vaginali

Attività
Presso Marilab Center Ostia
Presso Marilab Garbatella
Disponibile presso
Laboratorio generale di base con sezione specializzata di Microbiologia e Virologia
P
Presso MARILAB CENTER OSTIA - Viale A. Zambrini, 14 - Ostia (RM)
Direttore tecnico:
Dott. Luca Marino
Tel. 06 561951 Mail: zambrini@gruppomarilab.it
Laboratorio generale di base
SSN
Presso MARILAB GARBATELLA - Via Caffaro, 137 - Roma
Direttore tecnico:
Dott.ssa Concettina Latella
Tel. 06 5134191 / 06 51600997 Mail: caffaro@gruppomarilab.it
Laboratorio analisi
P
Presso FUTURE LABS - Via dei Castelli Romani, 2 – 00071 Pomezia (RM)
Direttore tecnico:
Dott. Luca Marino
Tel. 06 320934 Mail: info@marilabfuturelabs.it